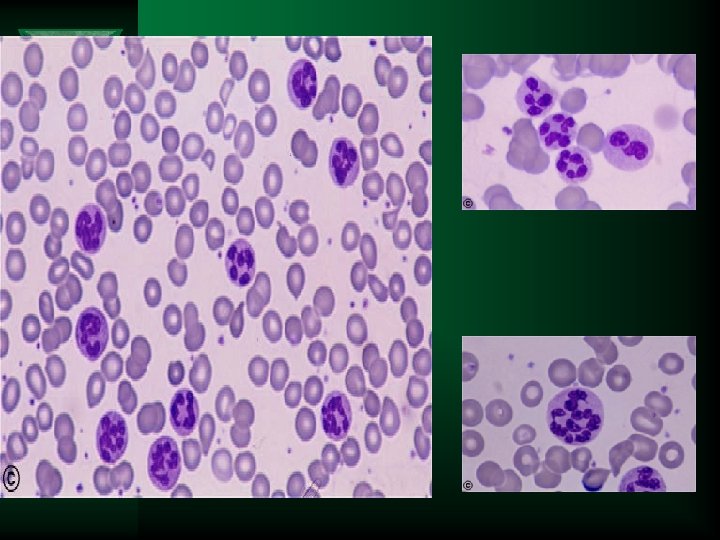

MACROCYTIC ANEMIAS Ahmad Sh Silmi Staff Specialist in











































































- Slides: 75

MACROCYTIC ANEMIAS Ahmad Sh. Silmi Staff Specialist in Haematology Medical Laboratory Sciences Dept, IUG 2012

Introduction Anemia classification based on the mechanism Ú Kinetic Classification (based on retic count) – Decreased production • Morpholgical classification (based on MCV) – Microcytic – Normocytic – Macrocytic – Increased destruction • Immunological classification (based on Coomb’s test) – Immune-mediated – Non-immune mediated

The Medical Student’s Approach to Anemia 1. Check the reticulocyte count to determine if the anemia is from decreased production (“hypoproliferative”, “reticulocytopenic”) or increased destruction (“hemolytic”)/acute blood loss (“reticulocytosis”) 2. If decreased production, narrow down the causes in terms of the MCV– If the MCV is low, then do iron studies then Hb electropheresis – If the MCV is normal, check the serum creatinine and TSH, if they are WNL then consider bone marrow exam – If the MCV is high check a folate and vitamin B 12 level 3. If the reticulocyte count is increased– Check a direct Coomb’s test 4. Look at the peripheral blood smear to confirm/support the diagnosis

Big Issue‼ Ú MCV=mean corpuscular volume

Anemia Algorithm Ú Patient with anemia and decreased reticulocyte count- What is the MCV ? ? Normocytic Microcytic Macrocytic: • Vitamin-related Fe def. Thal Systemic Diseases in Bone Marrow Renal vs. Liver vs. Endocrine vs. Anemia of Inflammation Other: sideroblastic anemia B 12, Folate • Non-vitamin: • MDS • Solid Tumor • Myeloma • Et. OH/Liver Disease • Aplastic anemia • Hypothyroidism

Anemia : MCV <80 Microcytic 80 -100 Normocytic >100 Macrocytic Defective hemoglobin synthesis Decreased production Defective DNA synthesis Megaloblastic anemia B 12 deficiency Folate deficiency Aplastic anemia Low Reticulocyte index Increased destruction High Iron deficiency (Fe 2+) Thalassemia (globin chain) Sideroblastic anemia (heme) Acute blood loss Hemolytic anemias Acquired Autoimmune HA Infectious disease Inherited Membrane defects Hereditary spherocytosis Hereditary elliptocytosis Enzyme defect/deficiency Glucose 6 phosphate dehydrogenase Pyruvate kinase Unstable hemoglobin Myelodysplastic Syndromes Young RBCs-reticulocytosis Hemolytic anemia Hypoplastic anemias Aplastic anemia

Requirements for Red Blood Cell Production Ú Erythropoeitin Ú Proteins, required for globin synthesis Ú Iron Ú Vitamin B 12 and folic acid Ú Vitamin B 6 Ú Vitamin C Ú Thyroid hormones, estrogens androgens

Definitions Ú Macrocytic – MCV > 100 • MCH is increased due to increased cell size • MCHC is normal as concentration of hemoglobin is normal Ú Macrocytosis is found in 2. 5 -4% of adults having a routine CBC Ú Sub classification – Megaloblastic – Non-megaloblastic

Macrocytic anemias Ú Megaloblastic – More severe macrocytosis with oval erythrocytes • Usually MCV is >110 – Defects in DNA syntheses leading to delayed nuclear development in the face of normal cytoplasmic development – Marrow shows nuclear cytoplasmic asynchrony • Erythroid lineage • Myeloid lineage – Reticulocyte index is not increased Ú Non-Megaloblastic – Less severe macrocytosis with round erythrocytes • Usually MCV is <110 – Pathophysiology unknown • Increase in membrane lipids – Immature cells (reticulocytes) are increased

Macrocytic anemias Ú Megaloblastic – B 12 deficiency – Folate deficiency – Drugs * – Megaloblastoid morphologic changes can be seen in • Myelodysplastic syndromes • Congenital dyserythropoietic anemias Ú Non-Megaloblastic * –– *– Alcoholism Liver disease Hypothyroidism – Aplastic anemia – Hemolysis, acute bleed • Increased reticulocytes and immature erythrocytes – Artifact • RBC clumping – cold agglutinin disease • Hyperglycemia – RBC swelling

MEGALOBLASTIC ANEMIA Ú These are a group of disorders in which the cause the anemia is due to deficiency of vitamin B 12 and folic acid Ú The macrocytes in this condition is usually “oval” - hence they are also called as MACRO OVALOCYTES

NON MEGALOBLASTIC MACROCYTIC ANEMIAS Ú Ú Ú 1. 2. 3. 4. 5. 6. These are disorders in which the macrocytosis is not due to vitamin B 12 or folic acid deficiency Here the macrocytes are “ROUND” The conditions in which such round macrocytes are seen are Reticulocytosis Hypothyroidism / myxedema Myelodysplastic syndrome Scurvy (Vit-C dif) Sideroblastic anemia Liver disorders

MEGALOBLASTIC ANEMIA Ú Vitamin B 12 and folic acid are important nutrients required in the process of nuclear maturation Ú They are required during erythropoiesis (during DNA synthesis) Ú These anemias may be caused because of a nutritional deficiency or impaired absorption mainly.

MEGALOBLASTIC ANEMIA Ú Impaired DNA synthesis leading to defective cell maturation and cell division Ú Nuclear maturation delays from the cytoplasmic maturation – NUCLEAR CYTOPLASMIC ASYNCHRONY Ú Abnormally large erythroid precursors and red cells

Ú Folic Acid: – It a vitamin which is yellow in colour, water soluble, necessary for the production of the RBC, WBC and platelets. – It is not synthesized in the body. – It is found in large number of green fresh vegetables, fruits. Ú Daily requirement: The human body needs about 100 -150 µg daily. Absorption: It is absorbed in the Duodenum and Jejunum. Ú Transportation: Weakly bound to albumin.

METABOLIC FUNCTION 1. Purine synthesis 2. Conversion of homocysteine to methionine ( which also requires B 12 )


FOLIC ACID DEFICIENCY 1. INCREASED DEMAND 2. DECREASED INTAKE 3. DECREASED ABSORPTION 4. METABOLIC INHIBITION

INCREASED DEMAND Ú Pregnancy Ú Lactation Ú Infancy Ú Puberty and growth period Ú Patients with chronic hemolytic anemias Ú Disseminated cancer

DECREASED INTAKE Ú Elderly Ú Lower socio economic status Ú Chronic alcoholics

DECREASED ABSORPTION Ú Acidic food substances in foods like legumes, beans Ú Drugs like phenytoin, oral contraceptives Ú Celiac disease which affect the gut absorption Ú Heat sensitive – more loss during cooking

METABOLIC INHIBITION

Vitamin B 12: Ú This vitamin is synthesized in nature by micro -organism in the intestine of man and animals, but we can not obtain it from the bacteria in our bodies, because it is synthesizing in the large colon after the site of absorption and it is wasted in the faeces in about 5µg/day. So we obtain it from animal food such as liver, kidney, meat and dairy products as milk and cheese.

VITAMIN B 12 Ú Abundant in animal foods Ú Microorganisms are the ultimate origin of cobalamin Ú It is stored in liver for many years Ú It is efficiently reabsorbed from bile Ú It is resistant to cooking and boiling

ÚDiary requirements: The human body needs about 1 -2 µg daily. ÚAbsorption: B 12 is combined with glycoprotein called the intrinsic factor (IF), which is synthesized in the gastric cells. The absorption occurs in the distal ileum. ÚTransportation: Transport by a protein synthesized in the liver called Transcobalamine II, which carry vitamin B 12 to liver, nerves and bone

VITAMIN B 12 DEFICIENCY Ú INCREASED REQUIREMENT Ú DECREASED INTAKE Ú IMPAIRED ABSORPTION

INCREASED DEMAND Ú Pregnancy Ú Lactation Ú Puberty Ú Growth period Ú Hyperthyroidism Ú Disseminated cancer

DECREASED INTAKE Ú Inadequate intake Ú Vegetarian diet

IMPAIRED ABSORPTION Ú INTRINSIC FACTOR DEFICIENCY due to chronic gastritis or antibodies against stomach cells. - PERNICIOUS ANEMIA - GASTRECTOMY Ú Malabsorption states Ú Diffuse intestinal diseases. Eg. , lymphoma, systemic sclerosis Ú Competitive parasitic uptake – fish tapeworm Ú Bacterial overgrowth

Pathophysiology Folates are compounds derived from folic acid that are involved in numerous metabolic reactions Generally folates act as donor of single carbon groups d. UMP=deoxyuridylate monophosphate DTMP=deoxythymidylate monophosphate One such reaction is thymidylate synthesis Defective thymidylate synthesis leads to defective DNA synthesis Megaloblastic anemia

B 12 and folate Ú B 12 is a known cofactor in 2 enzymatic reactions Ú (1) B 12 is a cofactor of methionine synthase which is required to regenerate folate within the cell

Other sequelae of B 12 deficiency Ú (2) Conversion of methylmalonyl Co. A and finally to succinyl-Co. A – Co factor for methylmalonyl Co. A – Failure of this pathway leads to abnormalities in neuronal membrane synthesis. • Also, methionine is a precursor for Sadenosylmethionine-a metabolite critical for normal function of the nervous system. – Neurologic defects seen with B 12 deficiency • Peripheral neuropathy – Disturbances of vibratory sense and proprioception • Dorsal and lateral column demyelination – Spastic ataxia • Brain – Dementia, psychosis, somnolence – Although anemia may respond to folate therapy, neurologic findings will not – Neurologic findings may be permanent if not treated early 1 Up-to-Date

Folate deficiency Ú Dietary sources – Present in animal and vegetable products • Asparagus, broccoli, spinach, lettuce, lima beans (>1 mg/100 g dry weight) • Liver, yeast, mushrooms, oranges • Cooking depletes food of folate Ú Metabolism – Absorbed most actively in the jejunum and upper ileum Ú Body stores are 5 -10 mg (liver) – Minimal daily intake is 50 micrograms • Higher for pregnancy and lactation – Folate deficiency can lead to birth defects (neural tube defects) – If intake is reduced to 5 micrograms/day, megaloblastic anemia will develop in ~4 months

Folate deficiency Ú Causes of folate deficiency – Decreased intake (most common) • Dietary deficiency – Infants on a Goat’s milk diet • Small intestinal disease – Tropical sprue – Celiac sprue (gluten sensitive enteropathy) – Increased requirement • • Pregnancy Alcoholism Hemolytic anemia Leukemia

B 12 deficiency Ú Dietary sources – Animal products (meat and dairy) Ú Metabolism – Ingested B 12 is protein bound – Trypsin and acid in stomach release B 12 – B 12 binds R-binding protein which carries it to the jejunum – Also in the stomach (fundus and body) intrinsic factor is secreted. – In the jejunum, pepsin releases B 12 from Rbinding protein – B 12 binds intrinsic factor and is carried to the ileum – B 12 is absorbed in the ileum Ú Body stores 2 -5 mg (mostly in the liver) – Need 3 -5 micrograms per day for maintenance of stores – Increased need in pregnancy, lactation, growth – Depletion takes longer that folate • It takes years to develop megaloblastic anemia due to B 12 deficiency

B 12 deficiency Ú Decreased intake – Veganism Ú Impaired absorption – Gastric • Poor stomach acidity • Gastrectomy • Pernicious anemia – Decreased secretion of intrinsic factor due to gastric atrophy – Chronic pancreatitis • Decreased digestive enzyme secretion – Intestinal disease • Ileal resection • Ileal disease – Chron’s disease – Celiac sprue • Fish tapeworm – Diphyllobothrium latum • Blind loop – Intestinal bacterial overgrowth

Diagnosis Ú Clinical findings Ú Morphology-peripheral blood and marrow – Megaloblastoid morphologic changes Ú Folate deficiency – Folate, serum level Homocystine • Reflects recent levels of ingestion • Falsely increased with hemolysis – RBC Folate MMA • Reflects stores (2 -3 months) • Will be decreased in B 12 deficiency Ú B 12 deficiency – Folate levels are decreased in B 12 deficiency, should check both in tandem – B 12, serum level • Serum methylmalonic acid and homocystine levels may be more sensitive – B 12 deficiency, both are elevated • sensitivity 94%, specificity 99% – Folate deficiency, only homocystine levels are elevated • sensitivity 94%, specificity 99% – May miss 10 -26% of patients with serum B 12 levels alone – Schillings test • Helps to identify the source of B 12 deficiency

Sequence of changes in megaloblastic anemia 1. Vitamin levels decrease 2. Neutrophil hypersegmentation 3. Oval macrocytosis in the peripheral blood 4. Megaloblastic changes in the marrow 5. Anemia

MEGALOPLASTIC ANAEMIA. ÚAffect all marrow elements. ÚNeurologic symptoms (dorsal columns) ÚIneffective erythropoiesis: High indirect bilirubin Very high LDH

Ineffective hematopoiesis Ú Because of the faulty megaloblastic maturation seen in the marrow, cells die during cell division Ú Hypercellular marrow due to erythroid hyperplasia with increased red blood cell precursors in the marrow but a macrocytic anemia in the periphery Ú Release of cell constituents – Increased bilirubin – Increased LDH

CLINICAL FEATURES Ú Patients develop all general symptoms and signs of the anaemia. Ú Knuckle pigmentation Ú Angular stomatitis Ú Atrophic glossitis- “beefy” tongue Ú Neurological disorders: sever deficiency of the folic acid causes neuropathies diseases. Ú Deficiency during pregnancy causes neural tube defect.

Diagnostic algorithm

Schillings test Allows one to determine the level at which B 12 deficiency is occurring Dietary deficiency Malabsorption Absence of intrinsic factor

Screening hematology laboratory tests for megaloblastic anemia Ú CBC – Macrocytic anemia • MCV is usually >110 f. L and often >120 f. L • Pancytopenia is seen in some cases Ú Peripheral blood morphology – Oval macrocytes – Nucleated RBCs, Howell Jolly bodies, basophilic stippling, Cabot rings – Neutrophil nuclear hypersegmentation • five 5 lobed neutrophils per 100 WBC • One six lobed neutrophil

Megaloblastic anemia: Morphology-Blood Normal Ú Peripheral blood – Macro-ovalocytes – Neutrophil nuclear hypersegmentation • Very sensitive and specific Megaloblastoid

Howell Jolly body - Round, dark, refractile RBC inclusion - Nuclear remnant - Most commonly seen in hyposplenism Basophilic stippling - Multiple small blue dots dispersed regularly throughout the RBC - RNA complexes Cabot ring - Ring shaped, thin - May be figure of 8 shaped - Microtubule, remnants of of the mitotic spindle - Rarely seen

PERIPHERAL BLOOD FINDINGS 1. 2. 3. 4. 5. 6. 7. 8. 9. 10. Hemoglobin – decreased Hematocrit – decreased RBC count – decreased/normal MCV - >100 fl ( normal 82 -98 fl) MCH –increased MCHC – NORMAL Reticulocytopenia. Total WBC count – normal / low Platelet count – normal/ low Pancytopenia, especially if anaemia is sever.

PERIPHERAL SMEAR Ú RBC: Ú Poikilocytosis - tear drops and schistocytes Ú Anisocytosis - oval macrocytes -Macro ovalocytes (macrocytic normochromic) -well hemogloibised, thicker than normal -inclusions like HOWELL JOLLY BODIES, basophilic stippling, Cabot rings

PERIPHERAL SMEAR Ú WBC: Normal count or reduced count Hypersegmented neutrophils (>5 lobes) MACRO POLYMORPHO NUCLEAR CELLS (Macropolys) Ú PLATELETS: Normal or decreased

BONE MARROW Ú Markedly hypercellular Ú Myeloid : erythroid ratio decreased or reversed. (Normally, there are three myeloid precursors for each erythroid precursor resulting in a 3: 1 ratio, known as the M: E (myeloid to erythroid) ratio) Ú Erythropoiesis : MEGALOBLASTIC

MEGALOBLAST 1. Abnormally large precursor 2. Deeply basophilic royal blue cytoplasm 3. Fine chromatin with prominent nucleoli 4. Nuclear cytoplasmic asynchrony 5. Abnormal mitoses 6. Maturation arrest

Megaloblastic anemias Morphology Ú Bone marrow – Nuclear cytoplasmic asynchrony in both erythroid and myeloid lineages Megaloblastic Normal Megaloblastic





BIOCHEMICAL FINDINGS Ú Increase in serum unconjugated bilirubin- because of ineffective erythropoiesis Ú Increase is LDH Ú Normal serum iron and ferritin

TESTS FOR FOLATE AND B 12 DEFICIENCY Ú Serum folate assay Ú Red cell folate assay Ú Serum B 12 assay

Pernicious Anemia Ú Decreased secretion of intrinsic factor due to gastric atrophy and loss of parietal cells Ú More common in individuals of Northern European descent greater than age 50 Ú Most common cause of vitamin B 12 deficiency Ú Diagnosis – Intrinsic factor antibodies (commonly blocks B 12 binding site) • Sensitivity 50 -84% • Specificity ~100% – Parietal cell antibodies • Less specific • ~50% sensitive

PATHOGENESIS Ú Immunologically mediated, autoimmune destruction of Ú Ú a) b) c) Ú gastric mucosa CHRONIC ATROPHIC GASTRITIS – marked loss of parietal cells Three types of antibodies: Type I antibody- 75% - blocks vitamin B 12 and IF binding Type II antibody – prevents binding of IF-B 12 complex with ileal receptors Type III antibody – 85 -90% patients – against specific structures in the parietal cell Associated with other autoimmune diseases like autoimmune thyroiditis

DIAGNOSTIC FEATURES 1. 2. 3. 4. 5. 6. 7. 8. 9. Moderate to severe megaloblastic anemia Leucopenia with hypersegmented neutrophils Mild to moderate thrombocytopenia Mild jaundice due to ineffective erythropoiesis and peripheral hemolysis Neurologic changes Low levels of serum B 12 Elevated levels of homocysteine Striking reticulocytosis after parenteral administration of vitamin B 12 Serum antibodies to intrinsic factor

Ú Therapy B 12 – Oral or intramuscular therapy – Both work well but IM is preferred for patients with an absorption problem Ú Folic acid – 1 -5 mg orally for one to four months (or till macrocytic anemia resolves) – Folic acid will correct the hematologic but not the neurologic sequelae of B 12 deficiency – !!!!!MUST rule out B 12 deficiency Ú Response – Reticulocytes rise after Day 4 and peak on day 5 -8 – Hemoglobin rises 2 -3 g/d. L every 2 weeks – Marrow begins to respond within days – Hypersegmented neutrophils may persist for up to 2 weeks

Non-megaloblastic macrocytic anemias Ú Ú Ú Alcoholism Liver disease Hemolysis, acute bleed Hypothyroidism Aplastic anemia Artifact – RBC clumping • cold agglutinin disease – Hyperglycemia • swelling

Alcohol Ú Common cause of macrocytosis – Regular ingestion of 80 g alcohol per day (1 bottle of wine) – Abstinence form alcohol leads to resolution of macrocytosis in 2 -4 months Ú ~90% of alcoholics have a macroytosis (100 -110 f. L) before anemia develops Ú Multifactorial in etiology – – Direct toxic effect Associated liver disease Reticulocytosis related to GI bleeding Co-incident folate deficiency

Ú Liver disease – Macrocytosis and target cells – Mechanism not well understood • May be related to increased lipid deposition on RBC membranes Ú Hyperlipidemia – Mechanism not well understood • May be related to increased lipid deposition on RBC membranes Ú Hypothyroidism – Mechanism unknown – ~10% of patients with autoimmune thyroiditis have pernicious anemia Ú Artifact – Hyperglycemia (>600) – RBC agglutination

Summary Ú Macrocytic anemias can be megaloblastic or non megaloblastic Ú Megaloblastic anemia has characteristic morphologic features – Nuclear cytoplasmic asynchrony Ú B 12 and folate deficiency are 2 reversible causes of megaloblastic anemia

Case Ú A 66 yo homeless man presents with generalized confusion, bruises and lacerations secondary to a witnessed fall down a flight of steps Ú Physical exam revealed a laparotomy scar Ú A CBC shows the following 7. 8 2. 108 24 • MCV 129 A peripheral blood smear is reviewed What additional laboratory tests would you like to request? http: //path. upmc. edu/cases/case 428. html

Ú ETOH Ú B 12 Ú Folate Ú RBC Folate Elevated 63 pg/m. L (211 – 911) 13. 2 ng/m. L (>5. 4) 805 ng/m. L(293 – 809) Diagnosis ? ? Megaloblastic anemia B 12 deficiency As the patient’s mental status cleared he reported that the scar on his abdomen was secondary to a partial bowel resection including a large segment of ileum

Case Ú 12 year old boy with no significant past medical history presents to his pediatrician with persistent poor appetite and weakness 1 week following an acute viral illness Ú He is found to be anemic Reticulocyte 9% What is the RPI? 10 5 180 30 • MCV 91 • MCHC 35. 9 [retic% X (Pt Hct/45)]/MAT = 1 + 0. 05(45 - Pt's HCT) ) (1. 75 in our case) [9% X (30/45)]/1. 75 RPI=3. 4

Additional labs and peripheral blood smear Haptoglobin Indirect bilirubin No increase in: Plasma hemoglobin Urine hemoglobin Extravascular hemolysis Splenomegaly on exam Of note, the mother had a similar peripheral blood smear